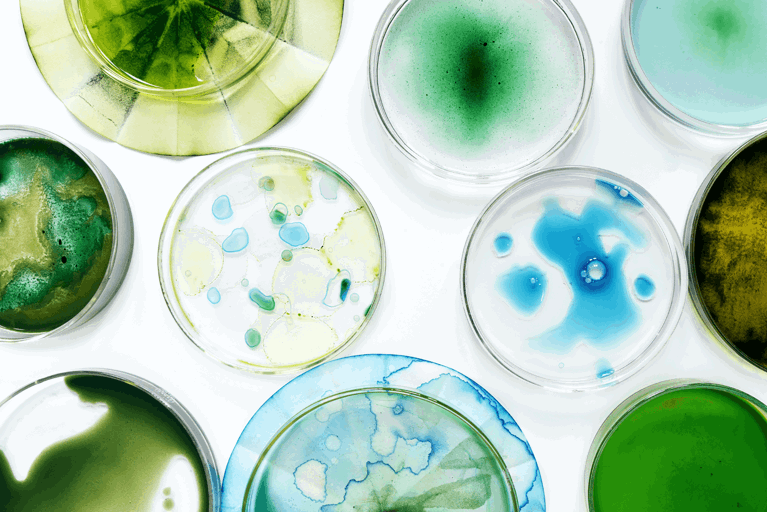
Microalgae colouration dye testing

Toi
Rauwhārangi

002
Ranked Design University
in Asia / Pacific 2025
94%
Of graduates gain employment
within six months.
2053
Students
2025 / 2026
1886
New Zealand’s oldest
design school.
Turn your talents into a lifelong creative career.